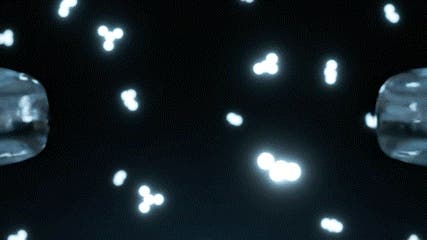

プロジェクト実行者
ストーリー
- 窓に“もう一枚の盾”。分子レベルで結合する史上初オーバーガラス技術が常識を覆す。※自社史上
- 豪雨も夜間も走行風で雨粒が消滅。分子融合の撥水テクノロジーが安全と爽快感を同時に叶える。
- 誰でも数分でプロ品質。ガラスに重なる新層が撥水と透明感を与え、一年先までクリアな視界を目指す。
【本プロジェクトはアンコールプロジェクト(*)です】
(*)アンコールプロジェクトとは、過去実施したプロジェクトが好評だった場合において、プロジェクト終了後から一般販売までに再び実施するプロジェクトを言います。
「オーバーガラス発想」──未来の視界を、今ここに。

SAPHILAS クォーツシールド
──それは、ガラスにガラスを塗るという新発想のシールド。

なぜ、今までのコーティングでは満足できなかったのか
雨の日に、運転中に感じるストレス。
・フロントガラスにこびりつく水滴

・夜間のライトで乱反射する視界

・ワイパーのビビり音や拭きムラ

簡易の窓用撥水剤は確かに便利だが、数週間で効果が薄れ、雨の日の安心感を支え続けることはできなかった。
一方で、プロ施工のガラスコーティングは高額で数時間を要し、気軽には手を出せない。
つまり市場には──
「簡単に施工でき、長期間続くプロ品質のガラスコート」がほとんど存在していなかったのだ。
SAPHILASの答え:「ガラスによる、ガラスのためのシールド」
私たちが出した答えは明快だ。
「ガラスを守るのは、ガラス自身が最も相応しい」。
SAPHILASのクォーツシールドは、ガラスと同じ成分=ケイ素由来成分を基盤にしている。
つまり、異物の膜ではなく“もう一枚のガラス層”を上から重ねるという発想。

その結果、ただ撥水するのではなく、ガラスそのものが進化したかのような圧倒的な透明度と耐久性を実現。


まさに「ガラスによる、ガラスのためのシールド」なのだ。
⸻
分子レベルで密着する
SAPHILAS クォーツシールドの最大の革新は、「ガラスと同じ成分を用いた分子レベルの結合」にある。
ガラスの主成分は 二酸化ケイ素(SiO₂)。
そして本製品の基盤成分も、同じくケイ素由来の特殊シラン化合物。
つまりこれは単なる“表面に乗る膜”ではなく、ガラス分子と化学的に結びつき、一体化する「第二のガラス層」。
その結果、
・長期間の耐久性
・剥がれにくい密着力
・施工直後から続く圧倒的な透明感
を実現した。
「剥がれる常識に、終止符。」
ガラス由来の“オーバーガラス”が、視界に革命をもたらす。
施工後は「ガラスの上にガラスを重ねた」ような超透明被膜。
従来のシリコン系、フッ素系のコーティングは柔らかく、ワイパーの摩擦によって劣化しやすい。
しかしSAPHILASは、ガラスにガラスを施工することで硬く強いシールドを形成。
ワイパーの動きにも強く、剥がれず、視界を守り抜く。

さらに「ガラス成分をのせると撥水が弱まる」という常識を覆し、撥水性・被膜強度・高耐久をすべて両立。

これこそが史上初の「分子レベルで結合するオーバーガラス技術」だ。
※自社史上
⸻
1. 科学的背景(オーバーガラス技術)
SAPHILASの秘密は「オーバーガラス」と名付けた科学的アプローチにある。
• 主成分:ケイ素由来の特殊シラン化合物
• 施工後:空気中の水分と反応し、強固なSi–O–Si(シロキサン結合)を生成
• 結果:ガラス表面に分子レベルで密着し、ナノ透明層を形成

この「ナノ透明層」こそが、もう一枚のガラス──オーバーガラス。
実験では、従来の撥水剤に比べ水滴接触角が大幅に増加。
さらに摩耗試験でも耐久性は2〜3倍。
(※当社比)
走行実験では、40km/hでも雨粒が滑り落ち、ワイパー頻度は半減。

科学と実体験、両方で証明されたテクノロジーが、ここに完成した。
⸻
2. オーバーガラスの正体:光学的チューニング
従来の撥水剤は「水を弾く」だけで終わっていた。
SAPHILAS クォーツシールドはさらに一歩踏み込み、「光学的に視界を最適化する」というアプローチを採用した。
• 透明度の最適化
ガラス層の屈折率を制御し、夜間ライトの乱反射を抑制。

• ギラつきゼロへ
通常の撥水で生じる“油膜のようなギラつき”を徹底排除。

• スベスベ化処理
拭き上げ時のクロスの摩擦抵抗が軽減され、施工ムラがゼロに。

その結果、昼夜問わず「まるで映画館のスクリーンのような」フラットでクリアな視界が生まれる。
単なる安全性能ではなく、“感動する視界” を体験できるのだ。

⸻
3. 得られる体験
クォーツシールドがもたらすのは、単なるコーティング効果ではない。
「運転そのものが変わる体験」 だ。
• 豪雨の中でも安心

街中を走行中、水滴が走行風で一瞬にして消える。
視界がクリアなまま保たれ、疲れにくい。
• 夜間走行の乱反射を低減

対向車のヘッドライトがギラつかず、まっすぐに視線を伸ばせる。
結果として、安全性が格段に向上する。
• 低速でも発揮される撥水力

窓用の撥水剤は高速走行時のみ効果を感じやすいものが多くあります。
しかしクォーツシールドは市街地の40km/hでも効果を実感。
毎日の通勤や買い物の中でも、安心が得られる。
• 輸入車特有のワイパービビり音を低減

輸入車の硬めのワイパーで生じやすい「ガガガ…」という不快音。
クォーツシールドのオーバーガラス層が摩擦を軽減し、静かな車内を実現する。
• 飛び石による微細傷の軽減

オーバーガラス層がクッションの役割を果たし、飛び石による微細な傷を低減。
見た目の劣化を防ぐだけでなく、リセールバリュー維持にも寄与する。
雨の日が待ち遠しくなる──そんな体験が現実になる。
⸻
4. 徹底比較
どれほど革新的であるかを理解するには、他手段との比較が一番分かりやすい。

結論:
「市販品の手軽さ」+「プロ施工の耐久・性能」。
その両方を兼ね備えた“ちょうどいい選択肢”こそ、SAPHILAS クォーツシールドなのだ。
⸻
5. 使用シーン紹介
SAPHILAS クォーツシールドの魅力は、日常のあらゆる瞬間で実感できる。

⸻
6. スペック詳細と施工手順
製品スペック

• 容量:100ml(フロントガラス約10枚分)
• 耐久性:6〜12ヶ月(環境により変動)
• 対応部位:フロント/サイド/リアガラス、ドアミラー、サンルーフ
• 施工時間:ガラス1枚につき約3分
使用方法
1. 洗浄・乾燥
汚れや水垢を落とし、完全に乾いた状態に。

2. 塗布
クロスにクォーツシールドを適量取り、均一に塗り広げる。

3. すぐに拭き取り
乾いたクロスでムラなく拭き取る。

4. 硬化
3分で被膜が定着。以後は雨天走行も可能。

ムラになりにくく、初心者でもプロ施工のような仕上がりが得られる。
⸻
7. 実際のユーザーの声

⸻
8. 開発ストーリー
クォーツシールドは、単なるケミカル製品ではない。
プロの現場で数千台の車を仕上げてきた職人たちの声から生まれた。
「ボディは輝いていても、ガラスが曇っていれば台無し」
「逆にガラスがクリアだと、車全体が新車のように見える」
この“真実”を形にするために、私たちは「ガラスを進化させる」という答えに辿り着いた。
研究に3年、テスト車両は200台以上。

ついに完成したのが「オーバーガラス技術=クォーツシールド」だ。

これは 「撥水剤」ではなく、「進化したガラス」。
Makuakeで応援いただく方だけが、いち早く体験できる未来の視界だ。
⸻
9. SAPHILASとは?

SAPHILAS(サフィラス) は、
「高級 × 最先端」を掲げるプレミアム・カーケアブランド。
• Sapphire(サファイア):硬さ・透明度・高級感の象徴
• Philos(フィロス):哲学・信念
この二つを掛け合わせ、
「揺るがない哲学で車の美を守る」という想いを込めている。
私たちは“製品”を売っているのではない。
「車と共に過ごす時間そのものをアップグレードする体験」を届けている。
その第一弾が、このクォーツシールドだ。
次世代カーケアを、日本から、そして世界へ。
⸻
10. 「あなたのガラスを未来に進化させる」
もう「雨の日は仕方ない」と我慢する必要はない。
SAPHILAS クォーツシールドが叶えるのは、「ガラスによる、ガラスのためのシールド」。
雨の日も、夜間も、飛び石の瞬間さえも──
あなたの愛車のガラスは進化し、未来のスクリーンへと変わる。

その第一歩を踏み出せるのは、
Makuakeを通じて応援してくださる、あなたです。
ぜひ、クォーツシールドと共に「未来の視界」を体験してください。
⸻
11. 実行者紹介
ジャパンリンクプロダクト株式会社(Japan Link Product co.,Ltd.)は、「最先端で高品質」を軸に、少し先の未来を形にするものづくりを行っています。
楽しさと驚きを大切に、日本から世界へ、世界から日本へと革新的な製品を届けることが私たちの使命です。
クラウドファンディングを通じて、まだ見ぬ体験を皆さまと共に創り上げ、グローバルに広がる新しい価値を提供してまいります。
リスク&チャレンジ
⚫︎現在、販売に向けて準備を進めておりますが、今後商品のデザインや色が一部変更になる場合がございます。 ⚫︎使用感等に関する返品・返金はお受けいたしかねます。 ⚫︎本製品は、あらゆる車両にテストし安全性を追求しておりますが、ご使用前に必ず目立たない箇所でテストを行ってください。ガラス面の状態や、過去に施工されたコーティング剤との相性によって、まれに影響が生じる可能性がございます。そのため、本製品の使用によって発生した損傷や不具合について、弊社では責任を負いかねますことをご理解ください。 ⚫︎製造スケジュールについては、現在プロジェクト成功を想定した数で調整しておりますが、想定を上回る応援購入の申し込みがあった場合、使用部材の供給状況、製造工程上の都合等により出荷時期が遅れる場合がございます。 ⚫︎一部国内に類似品が出回っている可能性がございます。弊社では他社の類似品に関してのお問い合わせには対応できませんので、ご了承ください。弊社商品のオリジナル性については、上記プロジェクトに関する情報をご覧ください。 ⚫︎本文中に記載のスケジュールは、あくまでプロジェクト公開時点の予定です。応援購入の性質上、配送遅延のおそれがございます。 原則として、配送遅延に伴う応援購入のキャンセルはできませんが、リターン配送予定月から3ヶ月を超えた場合には、希望者に限りキャンセルにて対応させていただきます。 ⚫︎商品出荷後、お客様ご都合による長期不在や住所不明により商品が返送されてしまった場合、再発送に伴う送料を頂戴しております。 ⚫︎プロジェクトページに掲載している内容に変更がある場合は、できるだけ早く活動レポートなどで共有を行っていく予定です。 ご質問等はお気軽に「実行者へ問い合わせ」よりメッセージくださいませ。 Makuakeの性質上、以上の注意点につきましてあらかじめご理解とご了承いただいた上で応援購入いただきますよう、よろしくお願い申し上げます。
サポーターからの応援コメント
文章のトップに戻る
応援購入する
このプロジェクトはAll in型です。目標金額の達成に関わらず、プロジェクト終了日の2026年02月27日までに支払いを完了した時点で購入が成立します。
決済時に安心システム利用料として2.2%(税抜)がかかります。
インボイス(適格請求書):対応可
【最速割】クォーツシールド2本
10,100円(税込)
※デザイン・仕様は変更になる可能性もございます。ご了承ください。
※ご注文状況、使用部材の供給状況、製造工程上の都合等により出荷時期が遅れる場合があります。
適格請求書発行事業者登録番号:あり
(適格請求書発行事業者登録番号の記載のあるインボイスが必要な場合は、Makuakeメッセージにて実行者に直接お問合せください)
インボイス(適格請求書):対応可
【複数割】クォーツシールド3本
13,600円(税込)
※デザイン・仕様は変更になる可能性もございます。ご了承ください。
※ご注文状況、使用部材の供給状況、製造工程上の都合等により出荷時期が遅れる場合があります。
適格請求書発行事業者登録番号:あり
(適格請求書発行事業者登録番号の記載のあるインボイスが必要な場合は、Makuakeメッセージにて実行者に直接お問合せください)
インボイス(適格請求書):対応可
【複数割】クォーツシールド5本
20,410円(税込)
※デザイン・仕様は変更になる可能性もございます。ご了承ください。
※ご注文状況、使用部材の供給状況、製造工程上の都合等により出荷時期が遅れる場合があります。
適格請求書発行事業者登録番号:あり
(適格請求書発行事業者登録番号の記載のあるインボイスが必要な場合は、Makuakeメッセージにて実行者に直接お問合せください)
インボイス(適格請求書):対応可
【複数割】クォーツシールド10本
34,990円(税込)
※デザイン・仕様は変更になる可能性もございます。ご了承ください。
※ご注文状況、使用部材の供給状況、製造工程上の都合等により出荷時期が遅れる場合があります。
適格請求書発行事業者登録番号:あり
(適格請求書発行事業者登録番号の記載のあるインボイスが必要な場合は、Makuakeメッセージにて実行者に直接お問合せください)
インボイス(適格請求書):対応可
【複数割】クォーツシールド30本
81,640円(税込)
※デザイン・仕様は変更になる可能性もございます。ご了承ください。
※ご注文状況、使用部材の供給状況、製造工程上の都合等により出荷時期が遅れる場合があります。
適格請求書発行事業者登録番号:あり
(適格請求書発行事業者登録番号の記載のあるインボイスが必要な場合は、Makuakeメッセージにて実行者に直接お問合せください)
インボイス(適格請求書):対応可
【最速割】クォーツシールド1本
5,630円(税込)
※デザイン・仕様は変更になる可能性もございます。ご了承ください。
※ご注文状況、使用部材の供給状況、製造工程上の都合等により出荷時期が遅れる場合があります。
適格請求書発行事業者登録番号:あり
(適格請求書発行事業者登録番号の記載のあるインボイスが必要な場合は、Makuakeメッセージにて実行者に直接お問合せください)
インボイス(適格請求書):対応可
「Makuake(マクアケ)」は、実行者の想いを応援購入によって実現するアタラシイものやサービスのプラットフォームです。このページは、 プロダクトカテゴリの 「【アンコール】豪雨が消え、夜が澄み渡る。オーバーガラス技術でドライブが進化!」プロジェクト詳細ページです。